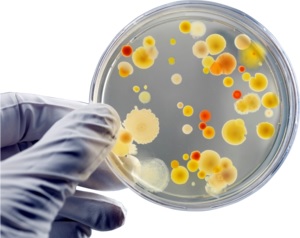

pH có ảnh hưởng đến nhận diện của môi trường nuôi cấy và khả năng phát triển của các vi sinh vật. Hầu hết các loại vi khuẩn phát triển ở pH 6,5-7,0 trong khi các tế bào động vật phát triển trong khoảng pH 7,2 - 7,4. Giá trị pH của các mẫu môi trường nuôi cấy ở nhiệt độ phòng có thể được đo sử dụng điện cực pH thủy tinh phẳng 6261-10C hoặc điện cực pH ISFET 0040-10D để đảm bảo chất lượng của mỗi đĩa.

Giới thiệu
Trong phòng thí nghiệm, các vi sinh vật như vi khuẩn, nấm men, nấm, tế bào động vật và tế bào thực vật được tạo điều kiện phát triển trong các môi trường nuôi cấy hoặc môi trường tăng trưởng thích hợp cho các xét nghiệm vi sinh khác nhau. Môi trường nuôi cấy chứa các chất dinh dưỡng, các yếu tố thúc đẩy tăng trưởng, nhiều nguồn năng lượng, muối đệm, khoáng chất, kim loại hay cả các chất làm rắn hoặc gel hóa (agar) để hỗ trợ sự phát triển và tồn tại của vi sinh vật. Hỗn hợp này có thể được chuẩn bị bằng cách trộn từng thành phần riêng lẻ hoặc mua sẵn ở thể bột khô và có thể điều chế thành thể chất lỏng, thể bán rắn, hoặc thể rắn (đĩa agar, ống thạch nghiêng, hoặc ống thạch sâu) phụ thuộc vào chất làm rắn hay chất gel hoá sử dụng. Các loại môi trường nuôi cấy khác nhau được thiết kế phù hợp cho các loại vi sinh vật và các ứng dụng cụ thể.
Ngoài sự phát triển hoàn thiện của các thành phần dinh dưỡng, pH chuẩn và ổn định cũng là một chỉ tiêu quan trọng đóng góp cho sự phát triển của vi sinh vật trong môi trường nuôi cấy. pH của môi trường nuôi cấy phù hợp sẽ giúp vi sinh vật phát triển. Hầu hết các vi khuẩn phát triển ở khoảng pH 6,5 - 7,0 trong khi tế bào động vật phát triển mạnh ở pH 7,2 - 7,4.
Do một số vi sinh vật như vi khuẩn có xu hướng giải phóng những sản phẩm axit có thể gây trở ngại cho sự phát triển của chúng, các chất đệm được thêm vào môi trường nuôi cấy để ổn định pH. Các nhà sản xuất môi trường nuôi cấy thường điều chỉnh giá trị pH trong môi trường cạn nước sao cho pH cuối của môi trường như được ghi trên nhãn sản phẩm khi giữ ở nhiệt độ 25°C.
Trước khi sử dụng, mỗi đĩa/ống môi trường phải trải qua kiểm soát chất lượng. Kiểm nghiệm hóa quan trọng nhất là đo pH, do ảnh hưởng của pH đến hiệu suất của môi trường nuôi cấy. Nếu pH của môi trường nằm ngoài phạm vi khuyến nghị, sự phát triển của các vi sinh vật và môi trường nuôi cấy sẽ bị ức chế, những chuyển đổi vật lý cũng có thể xảy ra như sự kết tủa của thành phần hoặc gel hoá. Việc kiểm tra pH thường xuyên trong môi trường nuôi cấy lỏng, bán rắn hoặc rắn có thể được tiến hành đơn giản bằng máy đo pH và điện cực pH sau khi hiệu chuẩn chính xác với bộ dung dịch đệm.
Điện cực pH phẳng, còn được gọi là điện cực pH đuôi hay điện cực pH bề mặt phẳng, thường được sử dụng để đo pH môi trường nuôi cấy, đặc biệt là dạng đĩa agar. Màng cảm biến và mối nối tham chiếu của điện cực pH phẳng được bố trí ở đầu điện cực. Cấu tạo đầu này rất phù hợp để đo pH của một giọt nhỏ hoặc một lượng nhỏ mẫu lỏng cũng như bề mặt ẩm của các mẫu rắn hoặc bán rắn như thịt, giấy, da, vải, pho mát, lá, da thuộc, bột mì và môi trường nuôi cấy.
HORIBA cung cấp hai loại điện cực pH phẳng dựa trên hai công nghệ điện cực khác biệt, điện cực pH thủy tinh phẳng tổ hợp 6261-10C và cực điện cực cảm biến nhạy ion hiệu ứng trường ion 0038-10C (ISFET). Phần nhạy trên thân điện cực pH thường là màng thủy tinh dựa trên công nghệ điện cực thủy tinh, còn bộ cảm biến của điện cực cải tiến được tạo nên dựa trên việc thu nhỏ chất bán dẫn sử dụng công nghệ bóng bán dẫn pH. 6261-10C là điện cực pH tổ hợp với thân thủy tinh có thể chống lại các tác động hóa học và mối nối có vỏ cứng giúp ngăn ngừa tắc nghẽn bởi tốc độ dòng tương đối cao so với mối nối gốm thông thường. 0040-10D được thiết kế với chip ISFET và thân không thủy tinh, rất bền, khó vỡ, dễ bảo quản và chống thấm nước. Những ưu điểm của 0040-10D và 6261-10C gồm:
Đặc tính của điện cực pH ISFET 0040-10D:
- Bộ cảm biến có thể thay thế, dễ vệ sinh bằng bàn chải mềm và có thể được bảo quản khô.
- Vật liệu epoxy lý tưởng dùng cho các ứng dụng và môi trường không thích hợp sử dụng vật liệu thủy tinh.
- Điện cực được tích hợp với cảm biến nhiệt độ để bù nhiệt tự động (ATC) và đọc pH chính xác.
- Mạch bảo vệ tĩnh điện được cải tiến để giảm hiệu ứng tĩnh điện.
- Phản ứng nhanh và các lỗi acidic hoặc alkaline trong điều kiện pH cực trị được giảm thiểu.
- Tự tắt khi không sử dụng.

Thiết lập thiết bị và hiệu chuẩn
Vì chỉ số pH phụ thuộc vào nhiệt độ, nên sử dụng một máy đo pH có khả năng truyền nhiệt. Nếu sử dụng điện cực pH 6261-10C, đo nhiệt độ các dung dịch đệm pH bằng nhiệt kế đã được hiệu chuẩn và nhập giá trị vào máy đo pH. Cách này sẽ cho phép máy đo pH bù lại ảnh hưởng của nhiệt độ trong quá trình hiệu chuẩn.
Sau khi hiệu chuẩn, slope phải nằm trong khoảng 95 - 105%. Nếu slope không nằm trong dải này, thay dung dịch đệm pH và vệ sinh, thấm khô / nhập lại giá trị nhiệt độ (chỉ áp dụng cho điện cực 6261-10C) và điều kiện sử dụng điện cực pH theo hướng dẫn sử dụng.
Chuẩn bị và đo mẫu
Đo pH của môi trường nuôi cấy ở nhiệt độ phòng (20 - 25°C) hoặc theo chỉ dẫn của nhà sản xuất môi trường. Để có được kết quả chính xác, các dung dịch đệm pH và mẫu phải ở cùng nhiệt độ.
Môi trường nuôi cấy trong phòng thí nghiệm phải được kiểm tra độ pH và điều chỉnh với 1M NaOH hoặc 1M HCl (nếu cần) trước khi đưa vào khử trùng. Kiểm tra lại độ pH sau khi khử trùng do có khả năng pH bị thay đổi. Ngược lại, các loại môi trường nuôi cấy bán sẵn thường không cần điều chỉnh pH nếu được chuẩn bị đúng cách, do đó chỉ phải đo pH của mẫu môi trường nuôi cấy sau khi đã được khử trùng. Đối với môi trường nuôi cấy trên môi trường agar, lấy kết quả pH của mẫu rắn.
Luôn giữ điện cực pH sạch. Sử dụng dung dịch làm sạch HORIBA 250 và nước ấm để loại bỏ dư lượng protein khỏi điện cực pH. Để biết thêm thông tin về làm sạch và bảo dưỡng, tham khảo hướng dẫn sử dụng điện cực.
Các bài viết tham khảo
Baird, R., Denyer, S. & Hodges, N. Handbook of Microbiological Quality Control in Pharmaceuticals and Medical Devices, p. 27.
Control of Microbiological Culture Media by Nordic Committee on Food Analysis. Retrieved from http://www.nmkl.org/dokumenter/prosedyrer/sk/PROC10_no.pdf on 25 September 2016.